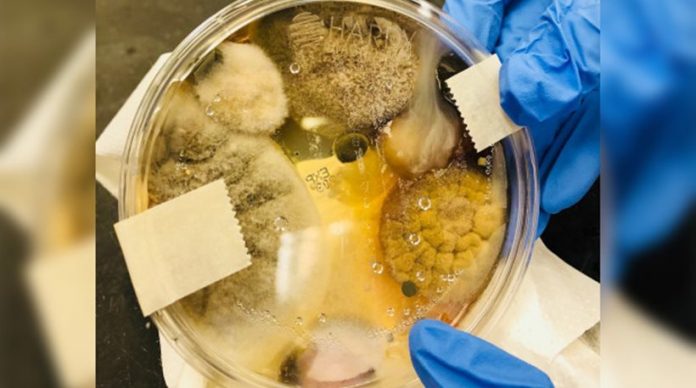

Viral έχει γίνει τα τελευταία 24ωρα η ανάρτηση μιας γυναίκας στο Facebook, που προειδοποιεί τους άλλους χρήστες ενάντια στη χρήση συσκευών για το στέγνωμα των χεριών σε δημόσιες τουαλέτες.
Η φωτογραφία που συνοδεύει την ανάρτηση εμφανίζει ένα τρυβλίο πέτρι, δηλ. ένα ρηχό πλαστικό πιάτο που χρησιμοποιείται από βιολόγους για την καλλιέργεια μικροοργανισμών. Στο εσωτερικό τους υπάρχει ένα αηδιαστικό σύμπλεγμα από μύκητες, που προκαλεί… «αναταράξεις» στο στομάχι.
«Ετοιμαστείτε να μείνετε άφωνοι», γράφει στο post της η Καλιφορνέζα Nichole Ward και συνεχίζει: «Αυτοί είναι οι μικροοργανισμοί που αναπτύχθηκαν στο τρυβλίο Πέτρι, μέσα σε δύο μέρες, αφού τοποθέτησα την άδεια επιφάνειά του κάτω από τον ζεστό αέρα ενός στεγνωτήρα χεριών για τρία μόλις λεπτά. Ναι μόνο 3 λεπτά. Μη στεγνώνετε ΠΟΤΕ τα χέρια σας σε αυτά τα μαραφέτια. Εκθέτετε τα χέρια σας σε στελέχη πιθανώς παθογόνων μυκητών και βακτηρίων και νομίζετε ότι φεύγετε από το μπάνιο πεντακάθαροι»
Η Ward ισχυρίζεται οτι πραγματοποίησε το πείραμά της σε έναν στεγνωτήρα Dyson Airblade και κατόπιν «καλλιέργησε» τα βακτήρια για 48 ώρες.
Μετά την «έκρηξη» του post, εκπρόσωπος της εταιρείας που κατασκευάζει τις συσκευές δήλωσε ότι οι εν λόγω στεγνωτήρες χρησιμοποιούνται εκτενώς σε νοσοκομεία και άλλα κρατικά ιδρύματα και εξέφρασε τις αμφιβολίες του για τη μεθοδολογία που χρησιμοποίησε η «ερασιτέχνης βιολόγος».